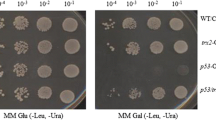

Abstract
Peroxiredoxins (Prxs) belong to a family of thiol-specific peroxidases that scavenge reactive oxygen species (ROS). Yeast Prx thiol-specific antioxidant (Tsa1) protects cells from oxidative stress and maintains genome stability. In this study, we investigated the role of Tsa1 in the response to DNA damage. We observed that Tsa1 among all five Prxs of yeast is the most responsive in cell viability and mutation rate assays. The Δtsa1 mutant is hypersensitive to DNA-damaging agents such as hydroxyurea, methyl methane sulfonate, and camptothecin. The Δtsa1 cells lead to reduced cell viability and cell growth after DNA damage. The Δtsa1-expressing wild-type Tsa1 rescues the sensitivity of Δtsa1 cells to DNA damage, but not in Δtsa1 cells carrying the active-site mutant Tsa1-C47S. We found that the level of ROS in Δtsa1 cells was increased more than in wild-type cells by DNA damage. Tsa1 completely restored the production of DNA damage-induced ROS in Δtsa1 cells, but not Tsa1-C47S. Finally, DNA damage-induced ROS resulted in a switch of Tsa1 from a low-molecular-weight to a high-molecular-weight complex. Taken together, these findings suggest that Tsa1 protects yeast cells from DNA damage by regulating the homeostasis of ROS through peroxidase activity.
Similar content being viewed by others
Introduction
Peroxiredoxins (Prxs) are a family of thiol-specific peroxidases that are widely involved in cell processes (Woo et al. 2003a). They are characterized as antioxidant enzymes that reduce hydrogen peroxide and alkyl hydroperoxides to water and alcohol, respectively (Chevallet et al. 2003; Woo et al. 2003a; Wood et al. 2003). All Prxs contain a conserved cysteine (Cys) residue at the N-terminus (the ‘peroxidatic’ cysteine) that is oxidized to a sulfenic acid (Cys-SOH) form by H2O2 (Chae et al. 1994a, b; Ellis and Poole 1997; Poole and Ellis 2002). Prxs can be divided into three subgroups (2-Cys Prx, atypical 2-Cys, and 1-Cys Prx) based on catalytic mechanisms and the number of Cys residues involved in catalysis (Kang et al. 1998; Seo et al. 2000; Rhee et al. 2001). The 2-Cys Prxs function as dimers and have an additional conserved C-terminal-Cys residue (the ‘resolving’ cysteine) (Kang et al. 1998). During the normal peroxidation reaction, the peroxidatic Cys residue of 2-Cys Prx is oxidized to Cys-SOH by H2O2 and reacts with resolving Cys residue from the other subunits of the dimer to form a disulfide (Chae et al. 1994a). This disulfide or sulfenic acid form is normally reduced by thioredoxin during the redox cycle (Chae et al. 1994a; b). During periods of oxidative stress, increased H2O2 influx causes hyperoxidation of N-terminal Cys sulfenic acid to sulfinic acid (Cys-SO2H), which leads to enzyme inactivation (Wood et al. 2003). Furthermore, the inactivation of 2-Cys Prxs can facilitate the formation of high-molecular-weight complexes and act as molecular chaperone (Jang et al. 2004; Moon et al. 2005; Jang et al. 2006).
The budding yeast saccharomyces cerevisiae contains five Prxs (Tsa1, Tsa2, Dot5, Ahp1, and Prx1) (Park et al. 2000). Tsa1 and Tsa2 belong to the 2-Cys Prx subgroup, but Tsa1 plays a key role in protecting yeast cells from oxidative stress (Wong et al. 2004). A mutator phenotype lacking one or several Prxs in yeast cells can be rescued by yeast Tsa1 or mammalian Prx1, but not by their active-site mutants defective in peroxidase activity (Wong et al. 2004; Iraqui et al. 2008). Under normal aerobic conditions, the absence of Tsa1 can result in spontaneous mutations and cell death through the production of endogenous reactive oxygen species (ROS) (Ragu et al. 2007; Iraqui et al. 2009). Tsa1 significantly contributes to genome stability and suppresses gross chromosomal rearrangements, base substitution, and frameshift mutations (Huang et al. 2003; Smith et al. 2004). Tsa1 is also required for cell survival that prevents defects in Rad6-meidated post-replicative repair, recombinational DNA double-strand break repair, and DNA replication checkpoints (Huang and Kolodner 2005). In addition, loss of Tsa1 has been shown to induce increased rates of mutagenesis and genomic instability by increasing dNTP production (Tang et al. 2009; Davidson et al. 2012).
Although the importance of Tsa1 in maintaining genome stability and cell survival has been extensively explored, the role of Tsa1 in response to DNA damage remains unknown. In the present study, we investigated the function of Tsa1 involved in the regulation of DNA damage response in yeast cells.
Materials and methods
Materials, yeast strains, and culture media
Saccharomyces cerevisiae BY4741 (MATa his3Δ0 leu2Δ0 met15Δ0 ura3Δ0) was grown in yeast extract peptone dextrose (YPD) medium (1 % yeast extract, 2 % peptone, and 2 % glucose). To investigate the role of yeast Prxs, yeast Prx deletion mutants (Δtsa1, Δtsa2, Δahp1, Δprx1, and Δdot5) were obtained from EUROSCARF (http://web.uni-frankfurt.de/fb15/mikro/euroscarf/). Hydroxyurea (HU), methyl methane sulfonate (MMS), camptothecin (CPT), canavanine, and 2′,-7′-dichlorofluorescein diacetate were purchased from Sigma (USA). Tsa1 and Tsa1-SO2/3 antibodies were produced as described previously (Woo et al. 2003b).
Plasmid constructs
To construct the TSA1 gene, a DNA fragment comprising the TSA1 open reading frame flanked by 500 bp upstream and 500 bp downstream sequences was polymerase chain reaction (PCR)-amplified and cloned into low-copy centromeric plasmid pRS415. Point-mutated Tsa1 (C47S) was generated using a PCR-based site-directed mutagenesis method. Mutagenized fragment was introduced into pRS415. All constructs used in this study were sequenced before use.
Measurement of cell viability response to DNA damage
To measure the sensitivity of yeast cells against DNA damage, yeast strains grown to mid-log phase were serially diluted with an initial optical density at 600 nm (OD600) of 0.6. Eight microliters from each dilution were spotted on solid YPD medium in the absence or presence of the indicated concentrations of DNA-damaging agents (HU, MMS, or CPT). The plates were incubated at 30 °C for 3 days.
Mutation rate assay
The number of cells mutated in yeast was determined based on fluctuation analysis, as described previously (Wong et al. 2004). Cells treated with 200 mM HU for 1 h were diluted and spread on YPD plates containing canavanine (60 mg/L) to identify mutations in CAN1. The number of colonies with canavanine resistance (Canr) was calculated. At least three independent cultures were analyzed.
Cell growth analysis
To analyze cell growth in the wild-type and ∆tsa1 yeast cells against DNA-damaging agents, cells grown overnight were inoculated to OD600 of 0.2 in YPD medium containing an indicated concentration of DNA-damaging agents. Every 4 h, duplicate measurements were taken from each sample, and the absorbance of the cells was measured at 600 nm. Growth analysis was repeated at least three times for each strain.
Detection of intracellular reactive oxygen species
Yeast strains were grown in YPD medium and diluted to OD600 of 0.5. Cells were incubated in the absence or presence of 50 mM HU for 60 min and treated with 1 mM 2′,-7′-dichlorofluorescein diacetate at room temperature for 10 min. The cells were washed with phosphate-buffered saline (PBS) and imaged under a confocal microscopy. DCF fluorescence intensity was calculated using 200 cells from each group.
Polyacrylamide gel electrophoresis and immunoblotting
Yeast cells were harvested and washed three times with cold PBS, lysed in lysis buffer (50 mM sodium phosphate, pH 7.4, 1 mM EDTA, 5 % glycerol, Xpert protease inhibitor cocktail, and Xpert phosphatase inhibitor cocktail), and broken using glass beads. After removing intact cells by centrifugation at 12,000 rpm for 15 min, the supernatants were obtained, and protein concentration was measured using the Bradford method. Proteins were then resolved by 10 % native-PAGE and 12 % sodium dodecyl sulfate–polyacrylamide gel electrophoresis (SDS-PAGE), and anti-Tsa1 and anti-Tsa1-SO2/3 antibodies were used for Western blot analysis.
Results
Yeast without Tsa1 is sensitive to DNA damage and shows elevated mutation rates
Yeast mutants lacking Tsa1 showed higher mutation rates in genome wide screens of yeast gene deletions (Huang et al. 2003; Smith et al. 2004). Tsa1 acts as a protector to maintain genomic stability by preventing spontaneous mutations and gross chromosomal rearrangements (Tang et al. 2009). To investigate whether yeast Prxs are involved in protecting cells against DNA damage, we examined the sensitivity of a yeast mutant lacking each of all five Prxs to DNA-damaging agents. Yeast mutant strains were verified by spotting serial dilutions of the cells onto media containing HU, a ribonucleotide reductase inhibitor that inhibits replication forks, or MMS, which leads to DNA methylation. Mutant strains lacking the cytosolic TSA1 gene or mitochondrial PRX1 gene showed sensitivity to both HU and MMS, comparable to that of wild-type cells in a dose-dependent manner. However, Δtsa2, Δahp1, and Δdot5 strains showed HU and MMS resistance similar to wild-type (Fig. 1A). Next, we determined the mutation rates of Prx mutants. This assay measured spontaneous mutations that inactivate the CAN1 gene and show resistance to canavanine. The Δtsa1 mutant showed higher mutation rates than the wild-type strain. In contrast, the mutation rates of the Δtsa2, Δahp1, Δprx1, and Δdot5 strains were not significantly changed (Fig. 1B). These results suggest that Tsa1 plays a central role protecting cells against DNA damage and suppressing the mutation. Thus, we focused on the role of Tsa1 in response to DNA damage.
The Δtsa1 mutant is sensitive to DNA damage and increases mutation rates. (A) Wild-type (WT) and Prx deletion mutants (Δtsa1, Δtsa2, Δahp1, Δprx1, and Δdot5) were serially diluted and spotted on solid YPD medium in the absence or presence of the indicated concentrations of HU or MMS. Plates were incubated for 3 days at 30 °C. (B) The cells treated with 200 mM HU for 1 h were spread on YPD plates containing canavanine (60 mg/L). The number of Canr cells was normalized with the total number of cells spread onto the plate. The mutation rate of WT cells was taken as 100 %. Results represent the average from three independent experiments
Tsa1 confers resistance to DNA-damaging agents
To further confirm the role of Tsa1 in the response to DNA damage, we examined the cell viability of Δtsa1 mutant compared to wild-type cells against DNA-damaging agents. The Δtsa1 mutant exhibited significant sensitivity to CPT, which induces the formation of double-stranded DNA breaks during DNA replication, in a dose-dependent manner (Fig. 2A). In addition, it was more hypersensitive to the other DNA-damaging agents (HU and MMS) than wild-type cells. To examine the effects of DNA-damaging agents on yeast cell growth, we tested their growth in wild-type and Δtsa1 mutant cells. As shown in Fig. 2B, when the cells were cultured in media containing CPT, MMS, or HU, the growth of the Δtsa1 mutant was inhibited compared to wild-type cells. These results indicate that Tsa1 is required for the growth and survival of yeast cells in response to DNA damage.
Tsa1 is required for the growth and survival of yeast cells response to DNA damage. (A) The serial dilution of WT and Δtsa1 cells were spotted on YPD medium containing the indicated concentrations of CPT, MMS, or HU. Plates were incubated for 3 days at 30 °C. (B) WT and Δtsa1 cells inoculated to OD600 = 0.2 in YPD medium were treated with CPT (5 μg/mL), MMS (0.01 %), or HU (200 mM), and cultured at 30 °C. The absorbance of the cells was measured at 600 nm every 4 h
Tsa1 peroxidase activity is required for cell survival after DNA damage
To investigate whether the peroxidase activity of Tsa1 is involved in controlling hypersensitivity to DNA-damaging agents, we employed the active-site mutant of Tsa1 (Tsa1-C47S), where peroxidatic cysteine was substituted with serine. Δtsa1 cells were transformed with a low-copy plasmid encoding wild-type Tsa1 or Tsa1-C47S, and their expressions were verified by Western blot analysis. Both wild-type Tsa1 and Tsa1-C47S were efficiently expressed in Δtsa1 strains (Fig. 3A). Transformed Δtsa1 cells were serially diluted and spotted onto media containing various concentrations of CPT, MMS, or HU. As shown in Fig. 3B, wild-type Tsa1 completely rescued the sensitivity of Δtsa1 cells to DNA-damaging agents. In contrast, Tsa1-C47S lacking peroxidase activity failed to rescue the sensitivity of Δtsa1 mutant to CPT, MMS, or HU, suggesting that the catalytic cysteine of Tsa1 is required for the resistance of yeast cells to DNA damage. These data indicate the importance of peroxidase activity of Tsa1 in protecting cells against DNA damage.
The peroxidase activity of Tsa1 is critical for protection of the cell from DNA damage. (A) Protein expression was detected by immunoblotting with anti-Tsa1 antibody in WT, Δtsa1, Δtsa1 carrying wild-type Tsa1, or Tsa1-C47S cells. (B) The serial dilution of WT (1), Δtsa1 (2), Δtsa1 carrying wild-type Tsa1 (3), or Tsa1-C47S (4) cells were spotted on plates containing the indicated concentrations of CPT, MMS, or HU. Plates were incubated for 3 days at 30 °C
Tsa1 suppresses the increase of DNA damage-induced ROS in yeast cells
Next, we considered the possibility that the catalytic activity of Tsa1 plays a key role in protecting cells from DNA damage-induced ROS. To address whether ROS levels were induced by treatment with DNA-damaging agents in yeast cells and whether Tsa1 could control DNA damage-mediated ROS, we examined the production of ROS induced by DNA damage using DCF fluorescence. As shown in Fig. 4A, Δtsa1 cells had a high level of intracellular ROS compared to wild-type cells. When wild-type Tsa1 was expressed in Δtsa1 cells, the DCF fluorescence decreased to levels similar to wild-type cells, but not Δtsa1 cells expressing Tsa1-C47S. After treatment with HU for 60 min, Δtsa1 cells showed a stronger increase in ROS levels than did wild-type cells. Moreover, wild-type Tsa1 suppressed the production of DNA damage-mediated ROS of Δtsa1 cells, but Tsa1-C47S did not suppress ROS production induced by DNA damage in Δtsa1 cells. This indicates that the peroxidase function of Tsa1 is essential for eliminating ROS produced by DNA damage in yeast cells.
Tsa1 inhibits the production of ROS by DNA damage in yeast cells. (A) WT, Δtsa1, Δtsa1 cells carrying wild-type Tsa1, or Tsa1-C47S were treated with or without 50 mM HU for 60 min. DCF fluorescence was measured with confocal microscopy, and the intensity of untreated WT was considered 100 %. Results represent the average from three independent experiments. (B) WT cells were treated with 50 mM HU for the indicated time or with 0.5 mM H2O2 for 10 min. Crude proteins were separated on native- and SDS-PAGE and subjected to immunoblotting with anti-Tsa1 and anti-Tsa1-SO2/3 antibodies
The structure of the Tsa1 protein was shifted from low-molecular weight (LMW) to high-molecular weight (HMW) complexes by H2O2 (Jang et al. 2004). Because the ROS levels were increased by DNA damage in yeast cells, the effects of DNA damage on Tsa1 structure were assessed by native-PAGE. As shown in Fig. 4B, the expression of Tsa1 protein itself was not affected by HU treatment in wild-type cells. Protein structure of Tsa1 is not as significant as structural changes by H2O2, but Tsa1 containing mainly LMW complexes under native conditions was slightly shifted to HMW complexes by HU treatment. Next, we examined the redox status of Tsa1 by SDS-PAGE and Western blotting using an anti-Tsa1-SO2/3 antibody. Tsa1 over-oxidation was significantly increased by HU treatment, such as in H2O2-treated cells (Fig. 4B). These results indicate that the structural changes in Tsa1 can be regulated by DNA damage-induced ROS.
Discussion
Our findings demonstrate that Tsa1 is required for cell survival response to DNA damage-induced ROS in yeast cells. Loss of Tsa1 showed increased mutation rates, which is consistent with that Tsa1 suppresses the accumulation of mutation and genome instability (Wong et al. 2004; Iraqui et al. 2008, 2009).
Although the sources of genome instability remain poorly understood, ROS production and oxygen metabolism were implicated in the prevalence of genome rearrangements (Park et al. 2000; Iraqui et al. 2009). ROS is a major cause of endogenous DNA damage; conversely, DNA damage intracellularly produces ROS (Rowe et al. 2008; Maynard et al. 2009). Our results showed that catalytic cysteine of Tsa1 is critical for hypersensitivity of cells to DNA-damaging agents such as HU, MMS, and CPT, suggesting that the hypersensitivity of Δtsa1 mutant may be primarily due to its peroxidase activity to scavenge ROS produced by DNA damage.
We observed that Δtsa1 mutant cells had higher baseline ROS levels and markedly increased the levels of ROS by DNA damage. Elevated ROS levels by DNA-damaging agents in Δtsa1 mutant cells were rescued by wild-type Tsa1, but not by Tsa1-C47S. Thus, loss of Tsa1 resulted in the sensitivity to DNA damage-induced ROS, and the peroxidase activity of Tsa1 reduced endogenous and exogenous ROS. This view was supported by our finding that the catalytic cysteine of Tsa1 was required for response to DNA damage stresses. In conclusion, these data suggest that Tsa1 protects yeast cells by regulating the levels of DNA damage-induced ROS via peroxidase activity.
References
Chae HZ, Chung SJ, Rhee SG (1994a) Thioredoxin-dependent peroxide reductase from yeast. J Biol Chem 269:27670–27678
Chae HZ, Uhm TB, Rhee SG (1994b) Dimerization of thiol-specific antioxidant and the essential role of cysteine 47. Proc Natl Acad Sci USA 91:7022–7026
Chevallet M, Wagner E, Luche S, van Dorsselaer A, Leize-Wagner E, Rabilloud T (2003) Regeneration of peroxiredoxins during recovery after oxidative stress: only some overoxidized peroxiredoxins can be reduced during recovery after oxidative stress. J Biol Chem 278:37146–37153
Davidson MB, Katou Y, Keszthelyi A, Sing TL, Xia T, Ou J, Vaisica JA, Thevakumaran N, Marjavaara L, Myers CL, Chabes A, Shirahige K, Brown GW (2012) Endogenous DNA replication stress results in expansion of dNTP pools and a mutator phenotype. EMBO J 31:895–907
Ellis HR, Poole LB (1997) Roles for the two cysteine residues of AhpC in catalysis of peroxide reduction by alkyl hydroperoxide reductase from Salmonella typhimurium. Biochemistry 36:13349–13356
Huang ME, Kolodner RD (2005) A biological network in Saccharomyces cerevisiae prevents the deleterious effects of endogenous oxidative DNA damage. Mol Cell 17:709–720
Huang ME, Rio AG, Nicolas A, Kolodner RD (2003) A genomewide screen in Saccharomyces cerevisiae for genes that suppress the accumulation of mutations. Proc Natl Acad Sci USA 100:11529–11534
Iraqui I, Faye G, Ragu S, Masurel-Heneman A, Kolodner RD, Huang ME (2008) Human peroxiredoxin PrxI is an orthologue of yeast Tsa1, capable of suppressing genome instability in Saccharomyces cerevisiae. Cancer Res 68:1055–1063
Iraqui I, Kienda G, Soeur J, Faye G, Baldacci G, Kolodner RD, Huang ME (2009) Peroxiredoxin Tsa1 is the key peroxidase suppressing genome instability and protecting against cell death in Saccharomyces cerevisiae. PLoS Genet 5:e1000524
Jang HH, Lee KO, Chi YH, Jung BG, Park SK, Park JH, Lee JR, Lee SS, Moon JC, Yun JW, Choi YO, Kim WY, Kang JS, Cheong GW, Yun DJ, Rhee SG, Cho MJ, Lee SY (2004) Two enzymes in one; two yeast peroxiredoxins display oxidative stress-dependent switching from a peroxidase to a molecular chaperone function. Cell 117:625–635
Jang HH, Kim SY, Park SK, Jeon HS, Lee YM, Jung JH, Lee SY, Chae HB, Jung YJ, Lee KO, Lim CO, Chung WS, Bahk JD, Yun DJ, Cho MJ, Lee SY (2006) Phosphorylation and concomitant structural changes in human 2-Cys peroxiredoxin isotype I differentially regulate its peroxidase and molecular chaperone functions. FEBS Lett 580:351–355
Kang SW, Baines IC, Rhee SG (1998) Characterization of a mammalian peroxiredoxin that contains one conserved cysteine. J Biol Chem 273:6303–6311
Maynard S, Schurman SH, Harboe C, de Souza-Pinto NC, Bohr VA (2009) Base excision repair of oxidative DNA damage and association with cancer and aging. Carcinogenesis 30:2–10
Moon JC, Hah YS, Kim WY, Jung BG, Jang HH, Lee JR, Kim SY, Lee YM, Jeon MG, Kim CW, Cho MJ, Lee SY (2005) Oxidative stress-dependent structural and functional switching of a human 2-Cys peroxiredoxin isotype II that enhances HeLa cell resistance to H2O2-induced cell death. J Biol Chem 280:28775–28784
Park SG, Cha MK, Jeong W, Kim IH (2000) Distinct physiological functions of thiol peroxidase isoenzymes in Saccharomyces cerevisiae. J Biol Chem 275:5723–5732
Poole LB, Ellis HR (2002) Identification of cysteine sulfenic acid in AhpC of alkyl hydroperoxide reductase. Methods Enzymol 348:122–136
Ragu S, Faye G, Iraqui I, Masurel-Heneman A, Kolodner RD, Huang ME (2007) Oxygen metabolism and reactive oxygen species cause chromosomal rearrangements and cell death. Proc Natl Acad Sci USA 104:9747–9752
Rhee SG, Kang SW, Chang TS, Jeong W, Kim K (2001) Peroxiredoxin, a novel family of peroxidases. IUBMB Life 52:35–41
Rowe LA, Degtyareva N, Doetsch PW (2008) DNA damage-induced reactive oxygen species (ROS) stress response in Saccharomyces cerevisiae. Free Radic Biol Med 45:1167–1177
Seo MS, Kang SW, Kim K, Baines IC, Lee TH, Rhee SG (2000) Identification of a new type of mammalian peroxiredoxin that forms an intramolecular disulfide as a reaction intermediate. J Biol Chem 275:20346–20354
Smith S, Hwang JY, Banerjee S, Majeed A, Gupta A, Myung K (2004) Mutator genes for suppression of gross chromosomal rearrangements identified by a genome-wide screening in Saccharomyces cerevisiae. Proc Natl Acad Sci USA 101:9039–9044
Tang HM, Siu KL, Wong CM, Jin DY (2009) Loss of yeast peroxiredoxin Tsa1p induces genome instability through activation of the DNA damage checkpoint and elevation of dNTP levels. PLoS Genet 5:e1000697
Wong CM, Siu KL, Jin DY (2004) Peroxiredoxin-null yeast cells are hypersensitive to oxidative stress and are genomically unstable. J Biol Chem 279:23207–23213
Woo HA, Chae HZ, Hwang SC, Yang KS, Kang SW, Kim K, Rhee SG (2003a) Reversing the inactivation of peroxiredoxins caused by cysteine sulfinic acid formation. Science 300:653–656
Woo HA, Kang SW, Kim HK, Yang KS, Chae HZ, Rhee SG (2003b) Reversible oxidation of the active site cysteine of peroxiredoxins to cysteine sulfinic acid. Immunoblot detection with antibodies specific for the hyperoxidized cysteine-containing sequence. J Biol Chem 278:47361–47364
Wood ZA, Poole LB, Karplus PA (2003) Peroxiredoxin evolution and the regulation of hydrogen peroxide signaling. Science 300:650–653
Acknowledgments
This research was supported by a grant from the Next-Generation BioGreen 21 Program (SSAC, Grant #:PJ01116601), Rural Development Administration, Republic of Korea.
Author information
Authors and Affiliations
Corresponding author
Rights and permissions
About this article
Cite this article
Cui, J., Lee, S.Y. & Jang, H.H. Yeast 2-Cys peroxiredoxin Tsa1 protects cells from DNA damage-induced reactive oxygen species through peroxidase activity. J Korean Soc Appl Biol Chem 58, 779–785 (2015). https://doi.org/10.1007/s13765-015-0107-x
Received:
Accepted:
Published:
Issue Date:
DOI: https://doi.org/10.1007/s13765-015-0107-x